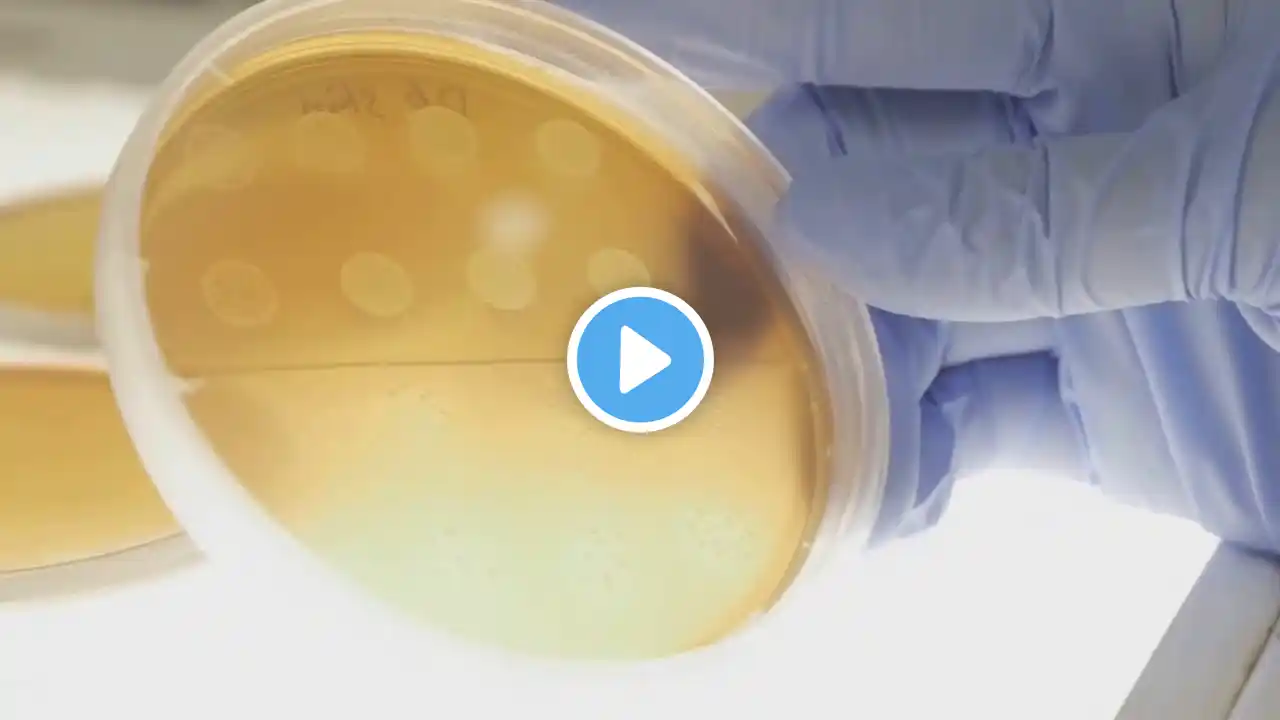
ภาพตัวอย่างวิดีโอ

Health officials warn of super flu surge as schools reopen
Health care officials are issuing a new warning about the super flu as children return to school, with the flu positivity rate in Oklahoma jumping more than 8% in just seven days. Read the story: https://okcfox.com/news/local/health-... Have a tip? Email us at [email protected] Have a video or photo you want to share? Upload it to okcfox.com/chimein/ www.okcfox.com TikTok: / fox25news Facebook: / foxokc Twitter: / okcfox Instagram: / okcfox Newsletter sign-up: https://okcfox.com/sign-up FOX 25 is an Oklahoma-based station and a FOX television affiliate owned and operated by Sinclair Broadcast Group. Sinclair owns and operates, programs or provides sales services to 163 television stations in 77 markets. Sinclair's television group reaches approximately 38.7% of US television households and includes FOX, ABC, MyTV, CW, CBS, NBC, Univision, and Azteca affiliates. #okc #oklahoma #news #fox25